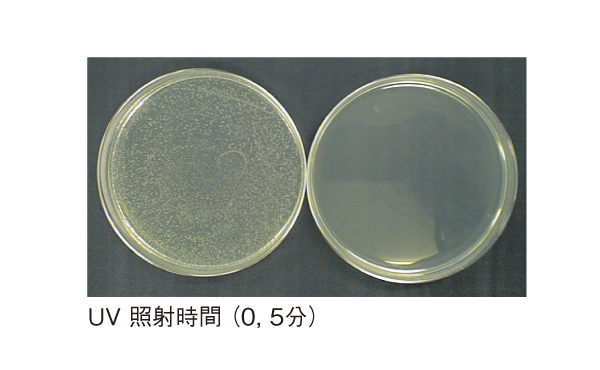

大容量リ-チイン・デザインで大量培養に最適
当社の「培養しながらコンタミネーション防止」メカニズム(海外・国内特許取得済)
細胞培養において、最大の“なやみ”はコンタミネーションです。温度制御技術が向上した現在、インキュベーター製造各社が、コンタミネーション防止機能を特長にしています。当社は、フィルターの交換作業や培養を中断して、予備のインキュベーターに細胞を移すといった、わずらわしい作業をすることなく、“培養しながらコンタミネーション防止”にこだわりました。
※対象機種: MCO-19AICUVH/19AICUV/5ACUV/20AIC/5MUV/19MUVH/19MUVはUVランプ標準装備。
MCO-19AIC/18AC/5AC/5M/80ICはUVランプオプション。
※器内は常に清潔な状態でご使用ください。
※銅合金ステンレスやUVランプ等の殺菌効果については、殺菌を保証する物ではありません。器内は常に清潔な状態でご使用下さい。
素早い環境復帰のために
速いCO2濃度復帰
IRセンサーと、CO2濃度のPID制御により、素早い復帰*を実現しました。(特許出願中)特に扉開閉頻度の高いユーザーの方々に、より安定したCO2濃度環境を提供するインキュベーターです。
*当社従来製品との比較
湿度の影響なく制御できるIRセンサー
CO2濃度制御には、湿度の影響を受けないIRセンサーを搭載しました。長寿命セラミック光源とチョッパーレス赤外線検出方式を採用。駆動部がないため、高い信頼性と精度が得られます。
コンタミネーション防止メカニズムの実証データ
銅合金ステンレスを採用し高い抗菌効果を実現
内装には、抗菌性能と耐腐食性に優れた銅合金ステンレスを採用。銅の高い抗菌作用とステンレスと同等の耐腐食性を兼ね備えています。また、培養物への悪影響もありません。
カビ繁殖テスト結果
器内をカビが非常に多い状態にして5ヶ月間経過後の状態です。ステンレスSUS-304の棚の上には多くのカビのコロニーが繁殖していますが、銅合金ステンレス製の棚の上にはカビのコロニーは発生していません。
 ※当社従来型インキュベーターの扉を24時間開放して培養。
※当社従来型インキュベーターの扉を24時間開放して培養。
コンタミネーション防止メカニズムの実証データ
培養細胞に対する安全性
- オゾンレスUVランプを採用
- 加湿トレイカバーによる培養エリアへのUV遮蔽構造
(反射による培養エリアへのUV漏れ量は室内蛍光灯照明時の机上レベル以下です)
- シャーレ・培養フラスコでのUV遮断
(シャーレ・培養フラスコの材料であるポリスチロールは50mmの厚さでUVを100%遮断します。右の写真はシャーレの蓋がUVを遮断し菌の増殖を妨げないことを示します)
加湿水に対するUVの効果(実機試験)
加湿水に対するUVの効果(実機試験)
 シャーレによるUV遮断効果(黄色ブドウ球菌の培養)
シャーレによるUV遮断効果(黄色ブドウ球菌の培養)
大容量リ-チイン・デザインで大量培養に最適
主な特長
- 大容量リ-チイン・デザイン
- 素早いCO2濃度復帰
- コンタミネ-ション防止構造
- 結露防止
- 全面二重ガラスドアで培養中サンプルの観察が容易です。
- 気密性の高いチヤンバー構造によりCO2ガス消費量を低減します。